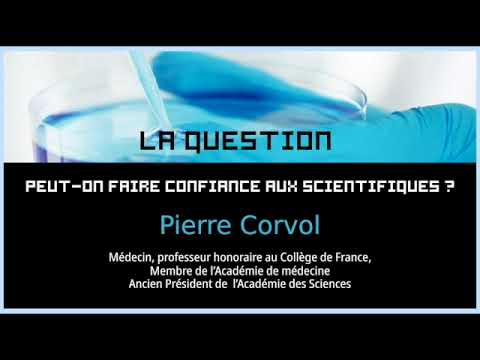
La Question : Faut-il faire confiance aux scientifiques ?

Nathalie Dompnier et le rôle de la conférence “Ma thèse en 180 secondes”
La présidente de l’Université de Lyon, Nathalie Dompnier, souligne l’importance d’événements tels que Ma thèse en 180 secondes pour construire la confiance en la science. Ce concours demande aux doctorants de présenter leurs travaux en seulement trois minutes, rendant ainsi la science accessible à un public non initié. 🌟
Cette initiative, née au Québec, est un exemple éclatant de communication scientifique réussie. Les étudiants sont mis au défi de vulgariser des concepts complexes, renforçant ainsi la crédibilité des innovations et découvertes. En un temps où la désinformation prolifère, cette approche directe et inclusive joue un rôle essentiel. Elle permet d’annihiler les barrières entre le monde universitaire et la société, promouvant une meilleure acceptation scientifique grâce à la transparence scientifique et à une compréhension approfondie des résultats. 🌍
Sur le meme sujet
Clermont-Ferrand : Un mariage entre art et science Dans le cadre enchanteur de Clermont-Ferrand, la fusion entre art et science…
Épistémologie : Une base pour comprendre la science
L’épistémologie, l’étude de la connaissance scientifique, est cruciale pour renforcer la confiance en la science. Elle aide à clarifier comment les connaissances scientifiques se forment et évoluent, offrant une perspective sur la manière dont les théories sont construites et testées.
Les jeunes apprenants peuvent être confrontés à des notions complexes, mais avec une explication adaptée, cette discipline devient un pilier de l’apprentissage. En mettant en avant les méthodes et processus, l’épistémologie apporte des outils pour distinguer les faits des opinions. Ainsi, les collégiens et lycéens sont encouragés à adopter une approche critique envers les informations qu’ils consomment, favorisant une culture scientifique robuste.
Sur le meme sujet
films de science-fiction incontournables pour les enfants dès 8 ans
Le voyage captivant dans l’univers de la science-fiction pour les jeunes Plonger les enfants dans l’univers des films de science-fiction…
La méthodologie scientifique : Une approche structurée
La méthode scientifique est un outil essentiel pour valider les hypothèses et renforcer la confiance du public. Ce processus rigoureux, basé sur l’observation, l’expérimentation et la validation, garantit que les résultats obtenus sont fiables et reproductibles. Dans un contexte éducatif, montrer aux étudiants l’application concrète de cette méthode est crucial.
Une compréhension claire de cette méthodologie permet de développer une approche analytique. Par exemple, en classe, les élèves peuvent reproduire des expériences simples pour observer directement l’impact des variables sur un résultat donné. Cette démarche active inspire confiance et démontre la solidité des résultats, rassurant ainsi le grand public sur la validité des découvertes scientifiques.
Sur le meme sujet
Pourquoi les objets tombent-ils toujours vers le sol : comprendre la gravité
Les principes de la gravité : une force incontournable L’une des questions les plus fondamentales de la physique est celle…
La communication scientifique au cœur de la confiance
Communiquer efficacement la science nécessite une stratégie bien définie. Il ne s’agit pas simplement de transmettre des informations, mais d’intégrer diverses techniques de vulgarisation pour créer une compréhension en profondeur. Utiliser des métaphores, des analogies et des illustrations engageantes constitue une approche efficace pour rendre les concepts complexes plus accessibles.
Par ailleurs, l’importance des médias sociaux ne peut être sous-estimée. Ils offrent une plateforme puissante pour diffuser des informations scientifiques vérifiées, permettant d’atteindre un public plus large. Les plateformes vidéo, par exemple, offrent des opportunités pour des démonstrations visuelles des concepts, augmentant ainsi l’intérêt et la compréhension du public. Cette dynamique de partage et d’éducation nourrit un dialogue ouvert, renforçant progressivement la confiance dans la science.
Exemples de réussite : Les doctorants de Lyon
Les initiatives locales, telles que les présentations des doctorants de Lyon dans “Ma thèse en 180 secondes”, sont des exemples concrets de succès en matière de communication scientifique. Chaque année, des doctorants prennent la scène pour présenter leurs travaux, mettant en lumière les compétences et le dévouement des chercheurs.
Parmi les participants, Célia Lacomme, doctorante en écologie évolutive, démontre comment les êtres vivants s’adaptent à leur environnement. Ce type de présentation engage le public, exposant les processus derrière les découvertes et les rendant tangibles. Ces expériences partagées constituent un puissant levier pour établir une acceptation scientifique plus large au sein de la société.
Transparence scientifique : Un pilier de la crédibilité
Pour renforcer la confiance, la transparence est clé. Elle implique que les données, protocoles et méthodes soient accessibles à tous. Les revues par les pairs jouent un rôle crucial dans cette démarche, car elles garantissent une vérification externe des travaux scientifiques avant publication.
Des initiatives comme les archives ouvertes permettent aux chercheurs de partager leurs travaux en accès libre, favorisant ainsi un échange de connaissances sans barrières. De même, les projets collaboratifs internationaux offrent des plateformes où les chercheurs peuvent travailler ensemble, partageant des techniques et des résultats. Cela renforce non seulement la crédibilité des études, mais assure également une mise en œuvre efficace de la rigueur scientifique, essentielle pour la confiance du public.
Science et société : Construire des ponts
La relation entre la science et la société est dynamique. Pour renforcer cette connexion, il est essentiel d’aborder les préoccupations sociétales directement par le biais de discussions et projets impliquant les citoyens. Ces activités participatives permettent de prendre en compte les besoins et interrogations du public, facilitant une compréhension mutuelle.
Un exemple concret est celui des ateliers d’intelligence collective, où des citoyens et des scientifiques travaillent ensemble pour résoudre des problèmes complexes. De telles initiatives non seulement engagent les participants, mais elles construisent également une relation de confiance durable. La science devient ainsi une ressource intégrée, visible et utile au quotidien de chacun.
Le rôle de l’éducation dans l’acceptation scientifique
L’éducation est au cœur du processus d’acceptation scientifique. Dès le plus jeune âge, les programmes scolaires doivent encourager la réflexion critique et l’analyse scientifique. Des exercices pratiques, des projets de recherche en classe et des jeux de rôle scientifiques peuvent rendre l’apprentissage stimulant et concret.
Par exemple, simuler un projet de recherche sur un thème environnemental permet aux élèves de se familiariser avec la méthode scientifique. Ils apprennent non seulement à poser des hypothèses, mais aussi à tester des variables de manière systématique. Cette approche formative prépare les jeunes à devenir des citoyens informés et critiques, capables de naviguer dans un monde où la science joue un rôle central. 🚀
FAQ sur la confiance en la science et son importance
Comment la science peut-elle regagner la confiance perdue?
Des initiatives comme ‘Ma thèse en 180 secondes’ et une communication transparente sont essentielles pour rétablir le lien entre la science et le public.
Pourquoi la transparence est-elle cruciale dans la recherche scientifique?
La transparence permet la vérification et l’acceptation des résultats scientifiques, renforçant ainsi la crédibilité auprès du public.
Quel est l’impact de l’éducation sur la perception de la science?
L’éducation scientifique, dès le plus jeune âge, prépare à une compréhension critique des informations, favorisant une confiance durable dans la science.
Claire Dubreuil, fondatrice de Sciences Box, enseigne la physique-chimie au collège depuis plus de 15 ans. Spécialisée dans la pédagogie active, elle crée des contenus clairs et motivants pour aider ses élèves à progresser. Elle est la voix éditoriale principale du site, qu’elle a conçu pour prolonger la salle de classe en ligne.